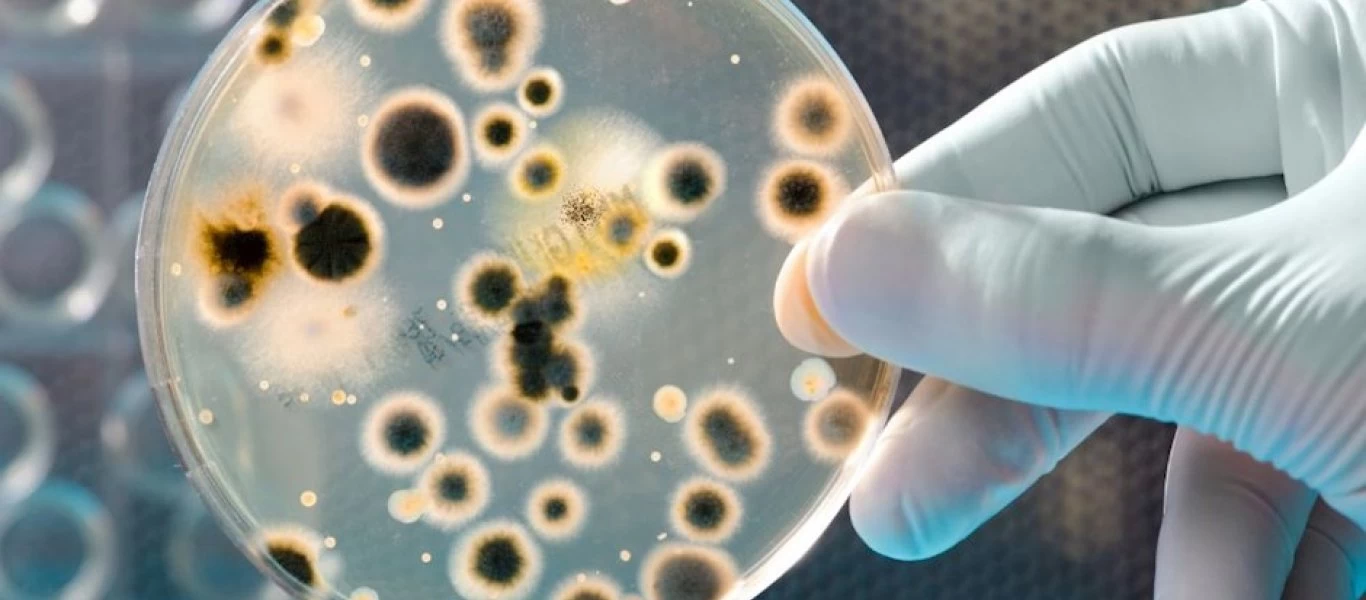
Τριχομονάδες: Το νου σας σε αυτά τα «ύπουλα» συμπτώματα - Ποια είναι σε γυναίκες και άντρες

ΥΓΕΙΑ
-

Sputnik V: Ξεκινά η παραγωγή του ρωσικού εμβολίου στη Σερβία
Το Ρωσικό Ταμείο Άμεσων Επενδύσεων (RDIF) ανακοίνωσε σήμερα, Πέμπτη, πως σύναψε συμφωνία με το Ινστιτούτο Torlak της Σερβίας για την παραγωγή στη χώρα του ρωσικού εμβολίου, Sputnik V.Η διαδικασία αναμ...
Read More » -

Επτά σπιτικά γιατροσόφια για να απαλλαγείτε από τις αιμορροΐδες με φυσικό τρόπο
Οι αιμορροΐδες είναι ένα μεγάλο πρόβλημα για όσους ανθρώπους το αντιμετωπίζουν, ειδικά για τους μεσήλικες, ενώ εκδηλώνεται με πρησμένους όζους στην έξοδο του παχέος εντέρου ή του ορθού.Αιμορροΐδες: Γι...
Read More » -

Όσα πρέπει να ξέρετε για τα υποκατάστατα ζάχαρης - Τι ισχύει για στέβια & φρουκτόζη
Πλέον στα ράφια των σούπερ μάρκετ, υπάρχουν αρκετές εναλλακτικές γλυκαντικές ουσίες με αποτέλεσμα να είναι πιο εύκολο να περιορίσετε την επιπλέον ζάχαρη στη διατροφή σας.Αλλά τι υποκατάστατα ζάχαρης υ...
Read More » -

Μ.Παγώνη: «Τα κρούσματα είναι πολλά όπως και οι εισαγωγές - Το χειρότερο είναι η ενδοοικογενειακή μετάδοση»
Η πρόεδρος της ΕΙΝΑΠ, Ματίνα Παγώνη, κατά τη διάρκεια συνέντευξής της, έσπειρε για ακόμη μία φορά τον τρόμο καθώς όπως είπε η μεταδοτικότητα των μεταλλάξεων του κορωνοϊού έχει αυξηθεί από 40% έως 60%....
Read More » -

Κορονοϊός - Παγώνη: Βρισκόμαστε σε κατάσταση πολέμου
Η πρόεδρος της ΕΙΝΑΠ έκρουσε τον κώδωνα στους νέους, καθώς όπως είπε, όλο και περισσότερα νεαρά άτομα νοσηλεύονται με κορονοϊό.Τον κώδωνα του κινδύνου έκρουσε, για ακόμα μία φορά, η Πρόεδρος της ΕΙΝΑΠ...
Read More » -

Έρευνα: Τελικά η δίαιτα ή η γυμναστική προστατεύει τις γυναίκες από τις καρδιαγγειακές παθήσεις;
Ερευνητές από το Πανεπιστήμιο της Καλιφόρνιας στο Λος Άντζελες των ΗΠΑ, προσπάθησαν να δώσουν απάντηση στο δίλημμα αν η δίαιτα ή η γυμναστική προστατεύουν περισσότερο τις γυναίκες από τις καρδιαγγειακ...
Read More » -

Κορονοϊός: Ποιο εμβόλιο προκαλεί εκτεταμένο δερματικό εξάνθημα – Πόσο ανησυχητικό είναι
Οι εξελίξεις τρέχουν για τα νέα εμβόλια έναντι της COVID-19, το ίδιο όμως συμβαίνει και όσον αφορά στοιχεία για αυτά που χρησιμοποιούνται ήδη στις εμβολιαστικές εκστρατείες.Ένα νέο δεδομένο για το mRN...
Read More » -

Σε τι είναι… χειρότερος ο μπακαλιάρος από τα άλλα ψάρια
Ο μπακαλιάρος εντάχθηκε πριν από αιώνες στο τραπέζι της 25ης Μαρτίου. Τι ισχύει για την θρεπτική αξία του. Σε τι υστερεί και πως μπορούμε να τον κάνουμε πιο υγιεινό.Την τιμητική του έχει σήμερα ο μπακ...
Read More » -

AstraZeneca: «Το εμβόλιό μας είναι 76% αποτελεσματικό»
Το εμβόλιο που ανέπτυξαν η AstraZeneca και το πανεπιστήμιο της Οξφόρδης για τον νέο κορωνοϊό είναι αποτελεσματικό κατά 76% στην πρόληψη συμπτωματικών κρουσμάτων, έκανε γνωστό σήμερα η βρετανοσουηδική ...
Read More » -
Τριχομονάδες: Το νου σας σε αυτά τα «ύπουλα» συμπτώματα - Ποια είναι σε γυναίκες και άντρες
Οι τριχομονάδες, που κάποιες φορές αναφέρονται και ως “τριχομονίαση”, είναι μια Σεξουαλικά Μεταδιδόμενη Νόσος (ΣΜΝ), η οποία προκαλείται από ένα μικροσκοπικό, μονοκύτταρο πρωτόζωο-παράσιτο, που ονομάζ...
Read More »
